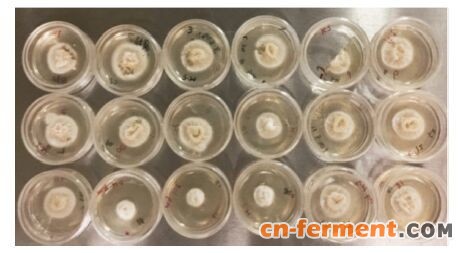

麦角菌 (Claviceps) 能够产生多种天然的、具有药用活性的麦角生物碱 (ergot alkaloid),具有广泛的临床用途[1]。很多天然或者半合成的麦角生物碱在现代医学中普遍使用,如麦角新碱用于催产和治疗产后出血; 麦角胺及其衍生物用于治疗偏头痛、产后止血; 麦角毒碱类用于治疗高泌乳素血症、与老龄化有关的神经退行性疾病等[2]。近年来,麦角生物碱的药理学活性已经得到了深入的研究,表明麦角碱通过与中枢神经系统中的多种受体相互作用而发挥其药理活性[3, 4]。
麦角菌Cp-1菌株系通过长期菌种选育得到,它可发酵生产麦角新碱和多种麦角肽碱,目前已投入相关企业进行生产。然而,在工业发酵生产中,该菌株常常能同时产生多种麦角碱,这为之后提取某种特定的药用麦角碱增加了纯化难度。因此若能基于基因工程等分子育种手段对该生产菌株进行遗传改造,使之定向生物合成某一类麦角生物碱,则具有重要的工业生产意义。由于麦角菌同种异株之间存在较大的遗传异质性,造成已建立的遗传转化体系在推广应用上的局限性,并且前期实验发现已报道的遗传转化体系并不适合Cp-1菌株。因此,针对该菌株建立遗传转化体系,对于今后对其开展分子生物学研究具有重要意义。原生质体的数量和质量是建立遗传转化体系的重要基础,本实验室曾建立了麦角菌原生质体制备与再生方法[5]。在此基础上,本文进一步优化了酶解条件,详细探讨了在不同菌丝体浓度和溶壁酶浓度及酶解时间下原生质体的形成情况,目的在于快速获得质量较佳的原生质体; 随后,利用PEG-CaCl2介导的方法实现了Cp-1菌株原生质体的转化,为今后利用该遗传转化体系对现有的Cp-1菌株进行分子遗传操作奠定了重要基础。
材料与方法菌株麦角菌Cp-1菌株为本实验室保存菌株。
质粒真菌表达质粒pAN7-1保存于本实验室; 该质粒带有hph基因 (潮霉素B磷酸转移酶基因) 且其上游和下游分别与3-磷酸甘油醛脱氢酶基因 (gdp) 强启动子和色氨酸酶C (trpC) 终止子连接,从而能在真菌中表达而具有对潮霉素的抗性。
培养基Cp-1菌株培养于T25D斜面培养基[5]; NL720液体培养基[5]; 原生质体细胞培养于再生培养基[5]; LB培养基 (0.5% 酵母提取物、1% 胰蛋白胨、1% 氯化钠、固体培养基加1.5% 琼脂)。
试剂与仪器潮霉素 (hygromycin B) 购于Sangon Biotech公司; 腐草霉素 (phleomycin)、遗传霉素 (geneticin) 购于Sigma公司; 溶壁酶 (lywallzyme) 购于广东省微生物研究所; DNA marker、Taq DNA聚合酶购于Tansgene公司; 其他试剂均为国产分析纯。PCR仪 (Eppendorf公司); Mini 2D型电泳仪 (Bio- Rad公司); 3K18型低温高速离心机 (Sigma公司); Biospectrum AV system凝胶成像仪 (美国UVP公司); HZQ-QX全温振荡摇床 (哈东联科学仪器有限公司)。
菌体培养菌种在斜面上培养7天后,取少量菌体捣碎并接于NL720液体培养基中,24 ℃、240 r·min-1条件下摇瓶培养3天,并按10% 接种量再次转接于NL720培养基,继续培养24 h。
不同酶解液浓度和酶解时间对原生质体制备的影响离心收集上述新鲜幼嫩的菌丝体,10 000 r·min-1,10~15 min,用无菌水洗涤菌体2~3次后,使用0.7 mol·L-1 KCl溶液作为渗透压稳定剂来重悬菌丝体,同时取25、50和100 mg溶壁酶溶于2 mL的0.7 mol·L-1 KCl溶液中,经0.22 μm滤膜进行过滤得到不同浓度的酶解液。随后,取1 g湿重的菌体溶于3 mL的0.7 mol·L-1 KCl溶液,并将上述2 mL酶解液分别加入3份上述菌液中进行酶解,此时酶解液终浓度分别为0.5%、1% 和2%,将其置于25 ℃、100 r·min-1的摇床上进行酶解,利用显微镜观察在不同酶解液浓度和酶解时间下原生质体的形成情况。
Cp-1菌株对不同抗生素的敏感性测试将Cp-1菌株的菌丝体接于T25D培养基上培养5~7天,待长满平板后,用直径0.5 cm的打孔器取相同面积的菌体转接于分别含有不同浓度的潮霉素 (hygromycin B)、腐草霉素 (phleomycin)、博来霉素 (bleomycin) 和遗传霉素 (geneticin) 的培养基上,待菌丝长满不含有抗生素的平板后,分别测定各平板菌丝体的直径,计算不同抗生素对Cp-1菌株的生长抑制率。
PEG介导的原生质体的转化利用无菌棉花过滤上述酶解液以除去残余菌丝体,于2 200 r·min-1、4 ℃条件下离心10 min,收集酶解后的原生质体,用0.85 mol·L-1的STC缓冲液 (0.85 mol·L-1山梨醇、10 mmol·L-1 Tris-HCl、50 mmol·L-1 CaCl2) 重悬原生质体使其浓度达到每毫升108个。取100 μL原生质体,加入10 μg待转化的质粒,另取100 μL原生质体,加入与上述质粒溶液等体积的ddH2O作为对照。用STC缓冲液补齐体积至200 μL,随后加入50 μL PEG溶液 (25% PEG 6000、10 mmol·L-1 Tris-HCl、50 mmol·L-1 CaCl2) 后,冰浴20 min,再加入2 mL PEG溶液,室温静置20 min,最后加入4 mL STC缓冲液,将上述悬液混于100 mL再生培养基中,于5个平板24 ℃下倒置避光培养7~9天,待其长出单菌落。
转化子的筛选挑取上述转化平板上的单菌落于新鲜含药培养基上,24 ℃下倒置避光培养5~7天后,挑取转化子的菌丝体提取基因组,少量提取基因组DNA的方法如下: 用干净牙签挑取少量的菌丝体于EP管中,加入500 μL裂解缓冲液 (400 mmol·L-1 Tris-HCl pH 8.0、60 mmol·L-1 EDTA pH 8.0、150 mmol·L-1 NaCl、1% SDS); PEG溶液 (25% PEG 6000、10 mmol·L-1 Tris-HCl、50 mmol·L-1 CaCl2); 60 ℃孵育20 min; 加入150 μL醋酸钾 (5 mol·L-1,pH 4.8) 溶液,剧烈涡旋,12 000 r·min-1离心5 min,取上清于新的EP管中; 加入等体积的异丙醇来沉淀DNA,12 000 r·min-1离心2 min; 弃上清,加入300 μL的70% 乙醇洗涤核酸沉淀,12 000 r·min-1离心1 min,弃上清; 自然风干去除乙醇后,用20~25 μL的ddH2O重悬,并加入2 μL RNase除去RNA。
按照pAN7-1质粒上hph基因 (潮霉素B磷酸转移酶基因) 抗性表达盒序列设计上下游引物: hph-F: 5'-CCAGGCTTTACACTTTATGC-3'; hph-R: 5'-GATG TGCTGCAAGGCGATTA-3'。分别以转化子和Cp-1野生型菌株的基因组DNA和pAN7-1质粒作为模板,使用引物hph-F和hph-R进行阳性转化子的鉴定。PCR反应体系为: 2×TransTaq-T SuperMix 8 μL; 上、下游引物 (10 μmol·L-1) 0.5 μL; 基因组DNA (10~30 ng·μL-1) 3 μL; ddH2O 4 μL。反应条件为94 ℃预热5 min,94 ℃变性30 s,52 ℃退火30 s,72 ℃延伸4 min 30 s,30个循环,72 ℃后延伸10 min。取5 μL PCR产物0.8% 琼脂糖凝胶电泳检测。
结果1 不同酶解液浓度和酶解时间对原生质体制备的影响使用浓度分别为0.5%、1% 和2% 的溶壁酶 (5 mL) 对相同湿重的Cp-1菌株的菌丝体 (约为1 g) 进行酶解,并在显微镜下观察酶解0.5、1和2 h后原生质体的形成情况。如图 1所示,使用不同浓度溶壁酶酶解0.5 h时,即有少量原生质体释放,但仍然存在大量菌丝; 随着酶解时间的增加,菌丝体逐渐被酶解完全,原生质体的数量逐渐增加。1 g菌丝体在使用0.5% 溶壁酶 (5 mL) 酶解2 h后,仍有少部分菌丝体未被酶解; 使用1% 溶壁酶 (5 mL) 酶解菌丝体2 h后,视野下可观察到大量球形的原生质体从菌丝体中游离出来,仅存在少量菌丝碎片; 在2% 高浓度酶解液的作用下,菌丝体酶解速率最快,在酶解1 h后仅有少部分菌丝体残余。考虑到已释放的原生质体与高浓度 的裂解酶长时间接触会导致其活力下降,以及节省溶壁酶成本,后期实验中作者使用优化后的酶解条件: 即选择1% 的溶壁酶 (5 mL) 酶解菌丝体 (1 g)、25 ℃、酶解2 h的条件快速制备大量原生质体。
![]() |
Figure 1 The release of protoplast under the different concentrations of enzyme and enzymatic time. Bar = 10 μm |
以抗生素为筛选标记建立遗传转化系统时,出发菌株对抗生素的敏感性至关重要。就Cp-1菌株而言,它并非营养缺陷菌株,故采用抗性筛选标记。本文分别测试了Cp-1菌株菌丝体对不同抗生素 (包括潮霉素hygromycin B、腐草霉素phleomycin、遗传霉素geneticin、博来霉素bleomycin) 的敏感性,取相同体积的菌丝体培养于各个含有不同浓度的抗生素的培养基,避光培养5~7天后,观察各种抗生素抑制菌丝体生长的情况。如图 2所示,随着潮霉素浓度的增加,Cp-1菌株的生长抑制率随之增加,当潮霉素浓度为1.5 mg·mL-1时,Cp-1菌株的生长已被完全抑制,因此,该浓度的潮霉素可作为转化体系中的筛选浓度。然而,Cp-1菌株对高浓度的腐草霉素 (500 μg·mL-1)、遗传霉素 (16 mg·mL-1) 和博来霉素 (1.0 mg·mL-1) 仅表现一定程度上的敏感性,并未能完全抑制其生长,因此并不适合作为筛选标记。
![]() |
Figure 2 The sensitivity of Cp-1 strain to different antibiotics |
利用PEG-CaCl2介导的方法将质粒pAN7-1转入100 μL Cp-1菌株的原生质体 (浓度为每毫升108个),而未转化质粒DNA组作为对照组; 将转化组和对照组在含1.5 mg·mL-1潮霉素的平板上避光培养7天左右后,可观察到转化组平板 (图 3A) 白色单菌落,而对照组无单菌落长出 (图 3B)。
![]() |
Figure 3 The colonies of transformants on medium containing 1.5 mg·mL-1 hygromycin B after transforming Cp-1 strain with pAN7-1 (A); and the negative control of transformation of Cp-1 strain (B) |
为了检测质粒pAN7-1是否转入Cp-1菌株中,从上述转化平板上随机挑取16个抗性转化子,重新接种于含1.5 mg·mL-1潮霉素的新鲜培养基上,避光培养5~7天,可观察到转化平板上的单菌落在含药培养基仍正常生长 (图 4)。用牙签挑取少量的菌丝体,提取各转化子的基因组DNA。随后,以各转化子的基因组 DNA作为模板,使用引物hph-F和hph-R进行PCR扩增,扩增后PCR产物进行琼脂糖凝胶电泳,如图 5所示,诊断PCR结果表明,以大部分转化子的基因组DNA为模板时 (除6、10、13和17号外),扩增得到的产物大小均与阳性对照中 (pAN7-1质粒为模板) 扩增得到的产物大小一致,均为4.3 kb左右; 而阴性对照 (野生型基因组 DNA作为模板时) 并未扩增得到目的条带。以上结果表明,质粒pAN7-1已成功转化Cp-1菌株,hph基因片段已整合在Cp-1菌株的基因组DNA上且发挥了抗潮霉素的功能。
![]() |
Figure 4 The growth of the transformants on fresh medium containing 1.5 mg·mL-1 hygromycin B |
![]() |
Figure 5 Identification of positive transformants by diagnosis PCR. M: Maker; 1: The genome of wild type strain as the template (negative control); 2: pAN7-1 as the template (positive control); 3-18: The genomes of different transformants as the template |
在建立真菌遗传转化体系时,原生质体的制备是至关重要的一步[6]。真菌原生质体的获得一般以刚萌发的孢子或者幼嫩的菌丝为材料,菌龄过老菌丝的细胞壁成分较为复杂,多会沉积不易被降解的物质,从而不利于原生质体的形成和释放[6, 7]。本课题组的前期研究结果也表明,菌丝体的生长状态对原生质体形成影响很大,幼嫩菌丝易于酶解释放原生质体,菌丝老化则较难酶解。因此,选择液体培养3~4天,转接后培养1天的幼嫩菌丝体来制备原生质体[5]。同时,由于真菌细胞壁成分比较复杂,选择合适的酶对于原生质体的制备尤其重要。已有的研 究报道通常选择使用β-D-葡聚糖酶 (β-D-glucanase enzyme)、Novozyme234、纤维素酶 (cellulase)、溶菌酶 (lysozyme) 或崩溃酶 (driselase) 等制备原生质体[6]。本课题组曾利用溶壁酶 (广东微生物所研制) 酶解菌龄较小的麦角菌菌丝,取得了良好的结果[5],这与很多大型真菌 (如草菇、香菇等) 利用此酶制备原生质体的结果较为一致[7-11]。本文在此基础上进一步确定了酶解时的Cp-1菌株菌丝体的用量、酶的浓度以及酶解时间,获得了适于遗传转化、质量较佳的原生质体。
有文献[12, 13,14, 15]报道在包括麦角菌在内的多种子囊菌中建立了遗传转化体系,然而由于子囊菌是一个非常庞大的类群,遗传背景千差万别,麦角菌的同种异株之间甚至表现出异质性,因此对于麦角菌Cp-1菌株的遗传转化体系具体建立条件仍需要摸索。例如,已有报道表明潮霉素对于麦角菌P1菌株的最低抑菌浓度为400 μg·mL-1 [15],但对于麦角菌Cp-1菌株的最低抑菌浓度高达1.5 mg·mL-1,两者相差近4倍; 更有甚者,腐草霉素对于麦角菌P1菌株的最低抑菌浓度仅为80 μg·mL-1,但对于Cp-1菌株而言,500 μg·mL-1腐草霉素却只能部分抑制Cp-1菌株的生长 (图 2)。又例如,遗传霉素抗性基因 (KanMX) 和博来霉素抗性基因 (ble) 常被用作真菌的遗传转化体系的建立[16, 17],但这两种抗生素均不能有效地抑制Cp-1菌株的生长。这些结果表明,在建立某种真菌的遗传转化体系并采用抗性基因作为筛选标记时,应通过筛选找到适合于该菌株的抗性标记及筛选浓度。本文将含有潮霉素抗性标记的pAN7-1质粒转化Cp-1菌株的原生质体,在潮霉素质量浓度为1.5 mg·mL-1的转化平板上观察到有大量转化子长出。更重要的是,诊断PCR结果表明潮霉素表达元件已整合到转化子的基因组中。
目前,Cp-1菌株已应用于工业生产麦角生物碱,但在生产过程中它产碱成分复杂,这为某些特定的药用麦角碱的获得带来了极大的困难。通过遗传改造技术来改变麦角碱生物合成途径中的代谢流,使其定向生物合成某种特定的麦角碱具有较高的实际应用价值,而Cp-1菌株遗传转化体系的成功建立,为后续获得更优良的工业生产菌株奠定了重要基础。
| [1] | Nina G, Lisa N, Paul T, et al. Biosynthetic pathways of ergot alkaloids[J]. Toxins, 2014, 6:3281-3295. |
| [2] | Wallwey C, Li SM. Ergot alkaloids:structure diversity, biosynthetic gene clusters and functional proof of biosynthetic genes[J]. Nat Prod Rep, 2011, 28:96-510. |
| [3] | Allers T, Ngo HP, Mevarech M, et al. Development of additional selectable markers for the halophilic archaeon Haloferax volcanii based on the leuB and trpA genes[J]. Appl Environ Microbiol, 2004, 70:943-953. |
| [4] | Haarmann T, Rolke Y, Giesbert S, et al. Ergot:from witchcraft to biotechnology[J]. Mol Plant Pathol, 2009, 10:56377. |
| [5] | Zhu P, He HX, Yue DC. Formation and regeneration of Claviceps purpurrea and Claviceps paspali[J]. Acta Mycol Sin (真菌学报), 1992, 11:272-278. |
| [6] | Ruiz-Diez B. Strategies for the transformation of filamentous fungi[J]. J Appl Microb, 2002, 92:189-195. |
| [7] | He QT, Zhang LY. Advances in the research on the technology of macro-fungi protoplast[J]. J Nanjing Xiaozhuang Coll (南京晓庄学院学报), 2001, 14:47-50. |
| [8] | Li G, Wang Q, Liu QY, et al. Establishment of a transformation system of Ganoderma Lucidum using PFG method[J]. Mycosystema (菌物学报), 2004, 23:255-261. |
| [9] | Zhu J, Zhang P. Optimizing conditions of preparing Pleurotus nebrodensiss protoplast[J]. Chin Agric Sci Bull (中国农学通报), 2011, 27:153-157. |
| [10] | Han YJ, Cao H, Chen MJ, et al. A study on the protoplast preparation, regeneration of Volvariella volvacea and the mutagenetic effect[J]. Acta Edulis Fungi (食用菌学报), 2004, 11:1-6. |
| [11] | Cheng Y, Bélanger RR. Protoplast preparation and regeneration from spores of the biocontrol fungus Pseudozyma flocculosa[J]. Microbiol Lett, 2000, 190:287-291. |
| [12] | Yao TT, Wang ZX. Preparation, regeneration and transformation of Aspergillus niger protoplasts[J]. J Food Sci Biotechnol (食品与生物技术学报), 2006, 29:116-120. |
| [13] | Zhang XL, Zheng XM, Man Y, et al. Preparation of protoplast for efficient DNA transformation of citric acid hyper-producing Aspergillus niger industrial strain[J]. Biotechnol Bull (生物技术通报), 2015, 31:171-177. |
| [14] | Janyce S, Yun C, Kwon C. Agrobacterium tumefaciensmediated transformation of Aspergillus fumigatus:an efficient tool for insertional mutagenesis and targeted gene disruption[J]. Appl Environ Microbiol, 2005, 71:1798-1802. |
| [15] | Victoriano G, Ulrike M, Paul T. Cloning, characterization, and targeted disruption of cpcat1, coding for an in planta secreted catalase of Claviceps purpurea[J]. Mol Plant Microbe Interact, 1998, 11:772-783. |
| [16] | Austin B, Hall RM, Tyler BM. Optimized vectors and selection for transformation of Neurospora crassa and Aspergillus nidulans to bleomycin and phleomycin resistance[J]. Gene, 1990, 93:157-162. |
| [17] | Walker ME, Gardner JM, Vystavelova A, et al. Application of the reuseable, KanMX selectable marker to industrial yeast:construction and evaluation of heterothallic wine strains of Saccharomyces cerevisiae, possessing minimal foreign DNA sequences[J]. FEMS Yeast Res, 2003, 4:339-347. |